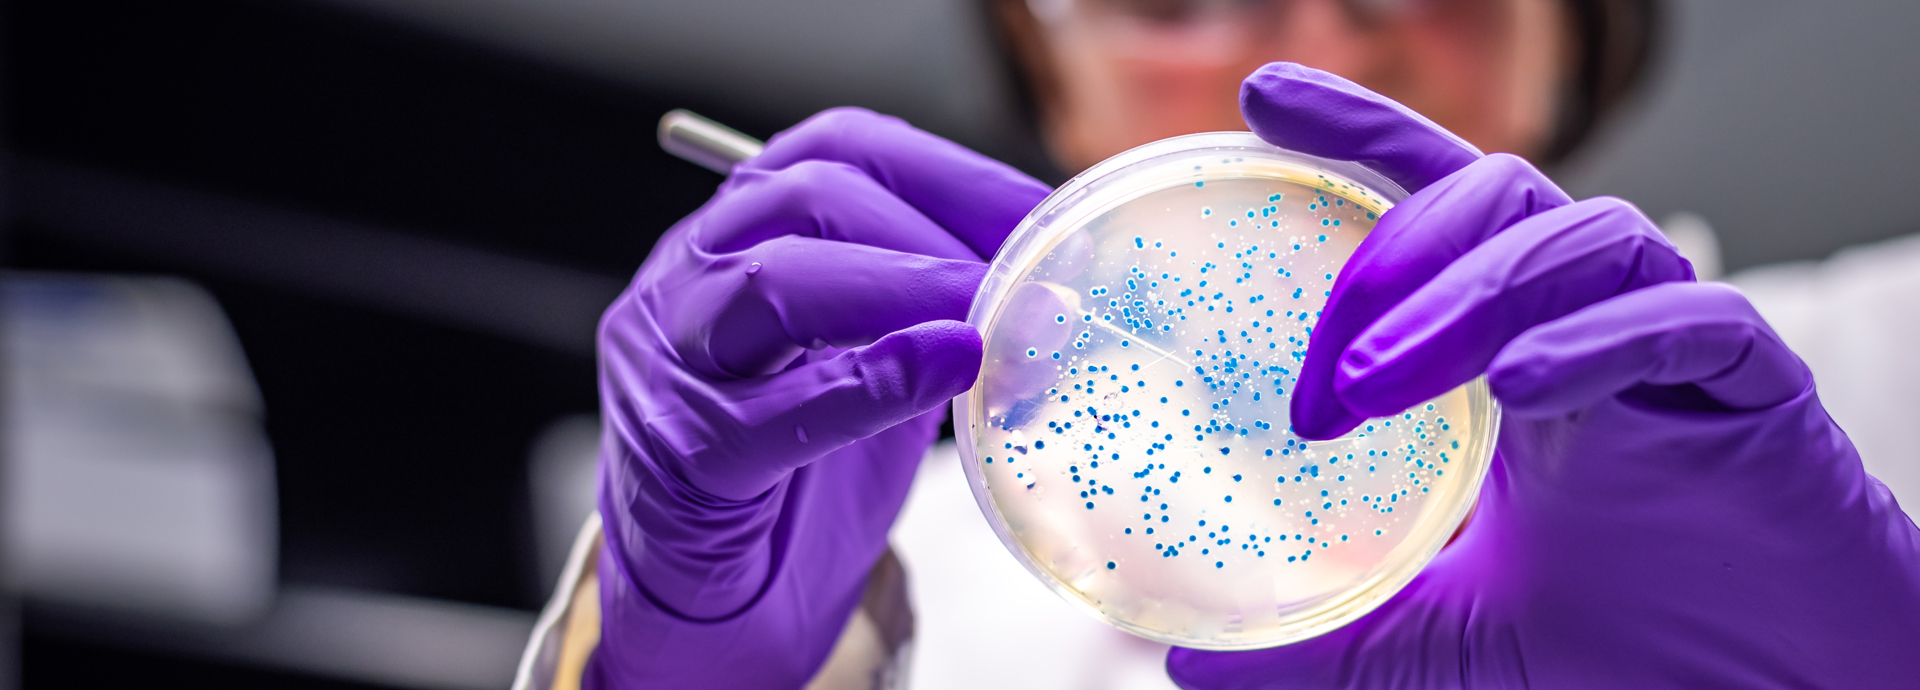
Animal Science

)
)
Royal Veterinary College
The Royal Veterinary College (RVC) is the UK's largest and longest-established independent vet school and is a Member Institution of the University of London.
Supporting bioscience innovation at LBIC since 2000
LBIC is owned and operated by the Royal Veterinary College (RVC), one of the independent colleges of the University of London and a world-class veterinary and biomedical research institute.
Our unique location enables LBIC clients’ opportunities for engagement with the RVC’s extensive scientific facilities, in addition to and research and contract research services including pre-clinical and clinical product development.
The RVC’s research mission is to create, communicate and apply scientific knowledge in order to improve the health and welfare of animals and people and the environments in which they live. Through conducting world-leading research and discovery in veterinary medicine, comparative biomedicine, One Health, disease biology, animal welfare, and allied disciplines.
RVC researchers work to better understand and treat disease, improve veterinary care and animal welfare, and tackle the global challenges of food security, climate change, and emerging pandemics. The RVC is a research-led institution, with 88% of its research rated as internationally excellent or world class in the Research Excellence Framework 2021.
Access to world-class research equipment, facilities and services
The RVC works closely with business and industry to advance scientific research and drive technological innovation. Through a range of partnership activities, it applies its leading scientific and clinical expertise to enhance the health and well-being of both humans and animals.
)
Collaborative research
The RVC collaborates globally with a range of partner organisations in areas related to human and animal health, and the pharmaceutical sector. The LBIC team work closely with RVC counterparts to encourage and facilitate new collaborations involving their clients and research teams.
)
Shared equipment
LBIC clients can access shared laboratory equipment at competitive rates, including confocal microscopy, RT-qPCR, real-time cell metabolic analysis, ultra-centrifugation, plate readers, gel imaging, nanodrop, dynamic light scattering, flow cytometry, and mass spectrometry .
)
Biological Services Unit
The RVC offers a comprehensive range of contract research services with high quality facilities and expertise, supporting various stages of pre-clinical and clinical product development within the regulatory and non-regulatory environment.
)
Bioscience graduates
RVC bioscience graduates bring a strong foundation in scientific research and animal health, making them a valuable source of talent for early-stage life science companies looking to progress their R&D activities. The team can advise on involving students with companies via industrial placement or sandwich year
)
Training
RVC offers introductory and advanced training opportunities. As just one example, RVC is one of the leading providers of Home Office courses for research training in the UK.
Access to RVC amenities
LBIC clients have access to the informal meeting spaces including the RVC’s Wi-Fi-enabled Lightwell café, for coffee, snacks and lunches.
)
)
)


